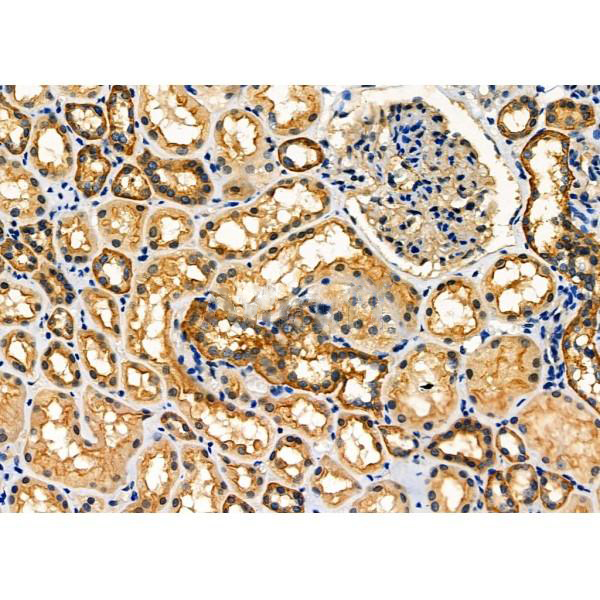

Catalyzes the hydrolytic deamination of adenosine and 2-deoxyadenosine. Plays an important role in purine metabolism and in adenosine homeostasis. Modulates signaling by extracellular adenosine, and so contributes indirectly to cellular signaling events. Acts as a positive regulator of T-cell coactivation, by binding DPP4. Its interaction with DPP4 regulates lymphocyte-epithelial cell adhesion. Enhances dendritic cell immunogenicity by affecting dendritic cell costimulatory molecule expression and cytokines and chemokines secretion (By similarity). Enhances CD4+ T-cell differentiation and proliferation. Acts as a positive modulator of adenosine receptors ADORA1 and ADORA2A, by enhancing their ligand affinity via conformational change. Stimulates plasminogen activation. Plays a role in male fertility. Plays a protective role in early postimplantation embryonic development (By similarity).
Description
Rabbit polyclonal antibody to ADA
Applications
WB, IHC.
Immunogen
ADA Antibody detects endogenous levels of total ADA.
Reactivity
Human, Mouse, Rat.
可预测:Pig(100%), Zebrafish(91%), Bovine(92%), Horse(92%), Sheep(100%), Rabbit(100%), Dog(83%), Chicken(91%), Xenopus(82%)
Molecular weight
41kDa; 41kD(Calculated).
Host species
Rabbit
Ig class
Immunogen-specific rabbit IgG
Purification
Antigen affinity purification
Full name
ADA
Synonyms
ada; ADA_HUMAN; ADA1; Adenosine aminohydrolase; Adenosine deaminase;
Storage
Rabbit IgG in phosphate buffered saline , pH 7.4, 150mM NaCl, 0.02% sodium azide and 50% glycerol. Store at -20 °C. Stable for 12 months from date of receipt.
Swissprot
P00813




 产品订购:
产品订购:
 渠道电话:
渠道电话: